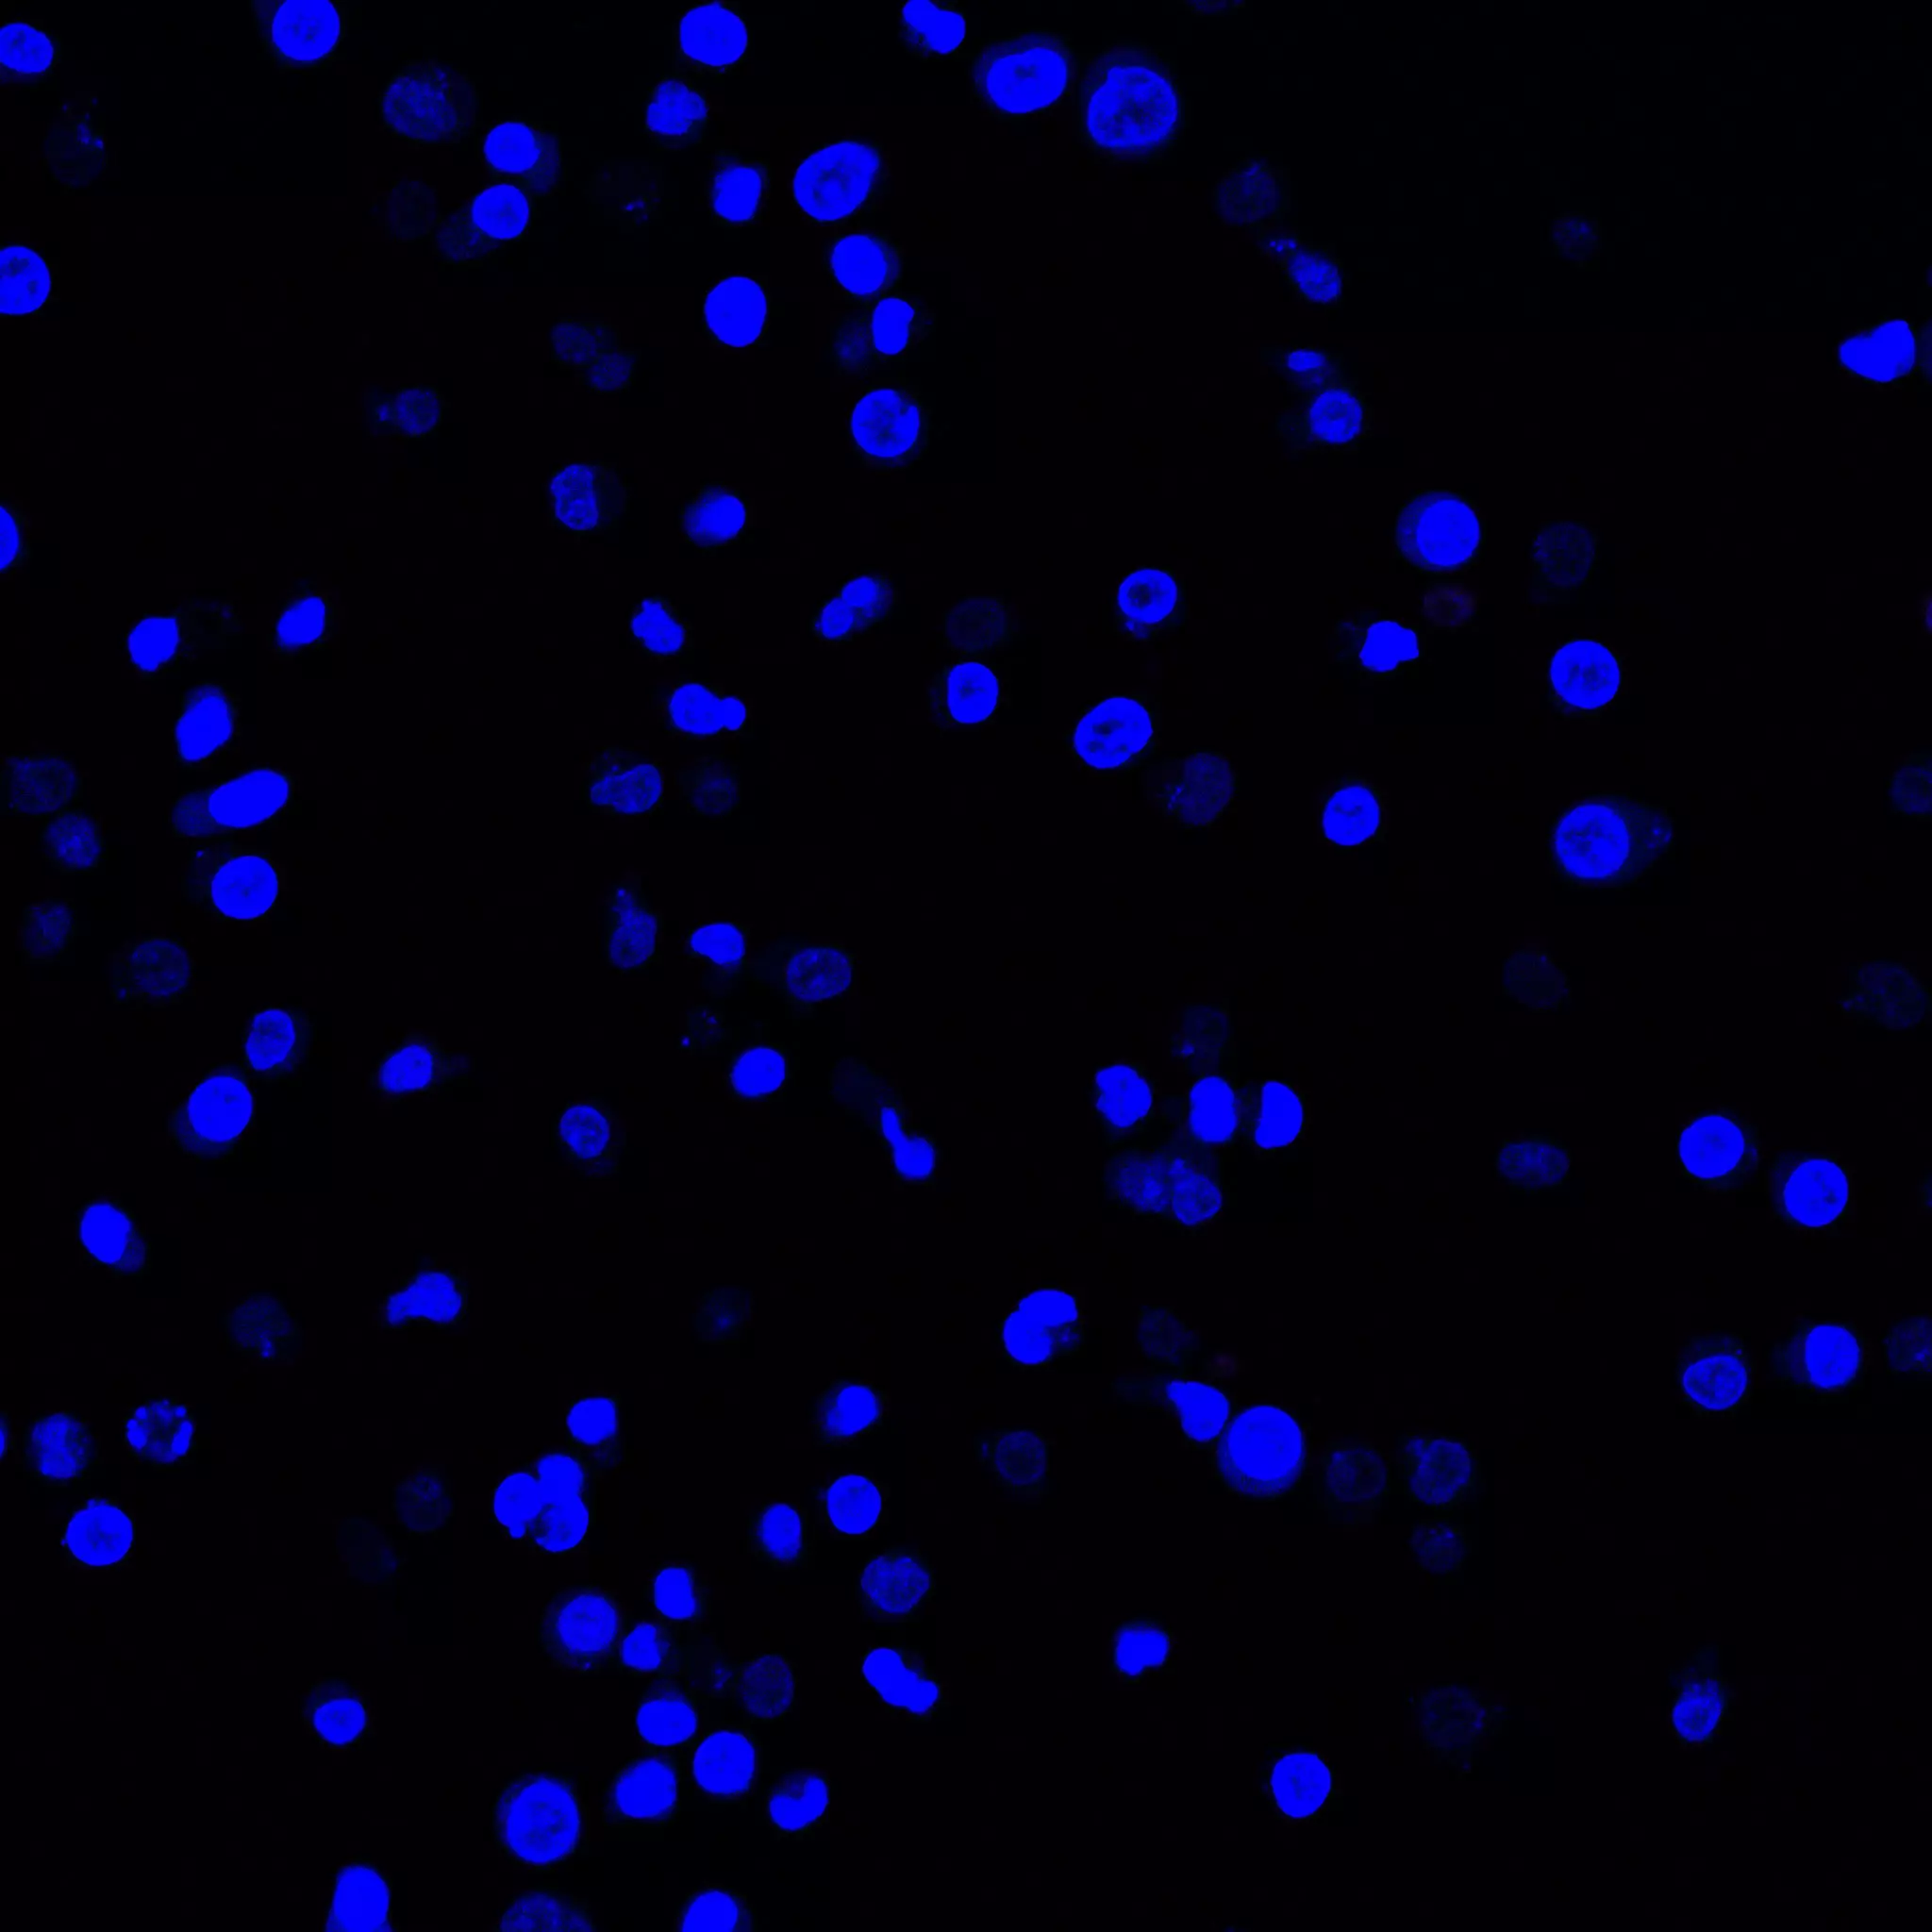
cd6864

product description:

F6864/1 â GC Shop Egypt

F6864/1 â GC Shop Egypt
Rio 2016: Favelas Close But 'So Far Away' From Olympics Spectacle cd6864 How to Counter Putin’s Subversive War on the West cd6864 Is Jeremy Corbyn The Brexit Camp's Secret Weapon cd6864 U.K. Tenants Will Bear The Brunt of Buy-to-Let Taxes Hike: Report cd6864
cd6864 Gold White Black Red Blue Beige Grey Price Rose Orange Purple Green Yellow Cyan Bordeaux pink Indigo Brown Silver
Product reviews:



Hugo
2025-11-19 iphone 7
Kid's Footwear Collection - Trade Sports cd6864
cd6864

Sebastian
2025-11-11 iphone 7 Plus
TLR4/CD284 antibody (98018-1-RR) | Proteintech cd6864
cd6864

Hamiltion
2025-11-20 iphone 6s Plus
CD644-67908 HP M570 / M575 Transfer Kit cd6864
cd6864

Customer Reviews:
| Full Name: | |
| Title: | |
| Description: | |
| Rating Value: | |
| Time: | 2025-11-20 16:42:09 |
Customers who viewed this item also viewed:


![[ëì´í¤] ëì´í¤ ìì´ë§¥ì¤ 90 LTR íì´í¸ GS - CD6864-108 - ëë (LUCK-D) cd6864](https://static.luck-d.com/product/17543/thumb_0914020948794231.png)





![EVALUATING THE AD6684 IF DIVERSITY RECEIVER [Analog Devices Wiki] cd6864](https://wiki.analog.com/_media/resources/eval/ad9694_jumpers_new_board.jpg)

![รัà¸à¸à¸£à¸°à¸à¸±à¸à¸à¸à¸à¹à¸à¹ รà¸à¸à¹à¸à¹à¸²à¹à¸à¸à¸µà¹à¹à¸à¹à¸à¸«à¸à¸´à¸ NIKE AIR MAX 90 LTR [CD6864 121] | Shopee Thailand cd6864](https://down-th.img.susercontent.com/file/th-11134207-7qul6-li8xy6l4fobs6e)













